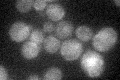
YDR305C
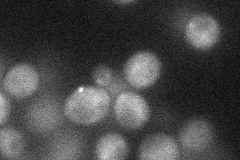
YDR305C
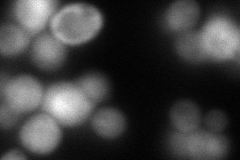
YDR305C
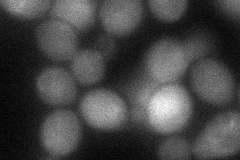
YDR305C
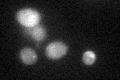
YDR305C
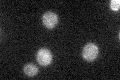
YDR305C

View description
Dinucleoside triphosphate hydrolase; has similarity to the tumor suppressor FHIT and belongs to the histidine triad (HIT) superfamily of nucleotide-binding proteins
Localization:
Intensity:
Fold change:
Significance:
-
C’ GFP library in SD
cytosol23.75 -
N' NOP1pr-GFP in SD
cytosol23.9909 -
N' TEF2pr-mCherry in SD
cytosolN/A -
N' NATIVEpr-GFP in SD

punctate16.2991 -
N' TEF2pr-VC and Cyto-VN in SD
cytosol45.4286 -
C’ GFP library in SD+DTT
cytosol27.421.15No -
C’ GFP library in SD+H2O2

cytosol21.460.9No -
C’ GFP library in Starvation Media
cytosol28.821.21No -
C’ GFP library on the background of Pup2-DaMP

cytosol -
C’ GFP library on the background of CCT mutant

cytosol25.01771.05321No
